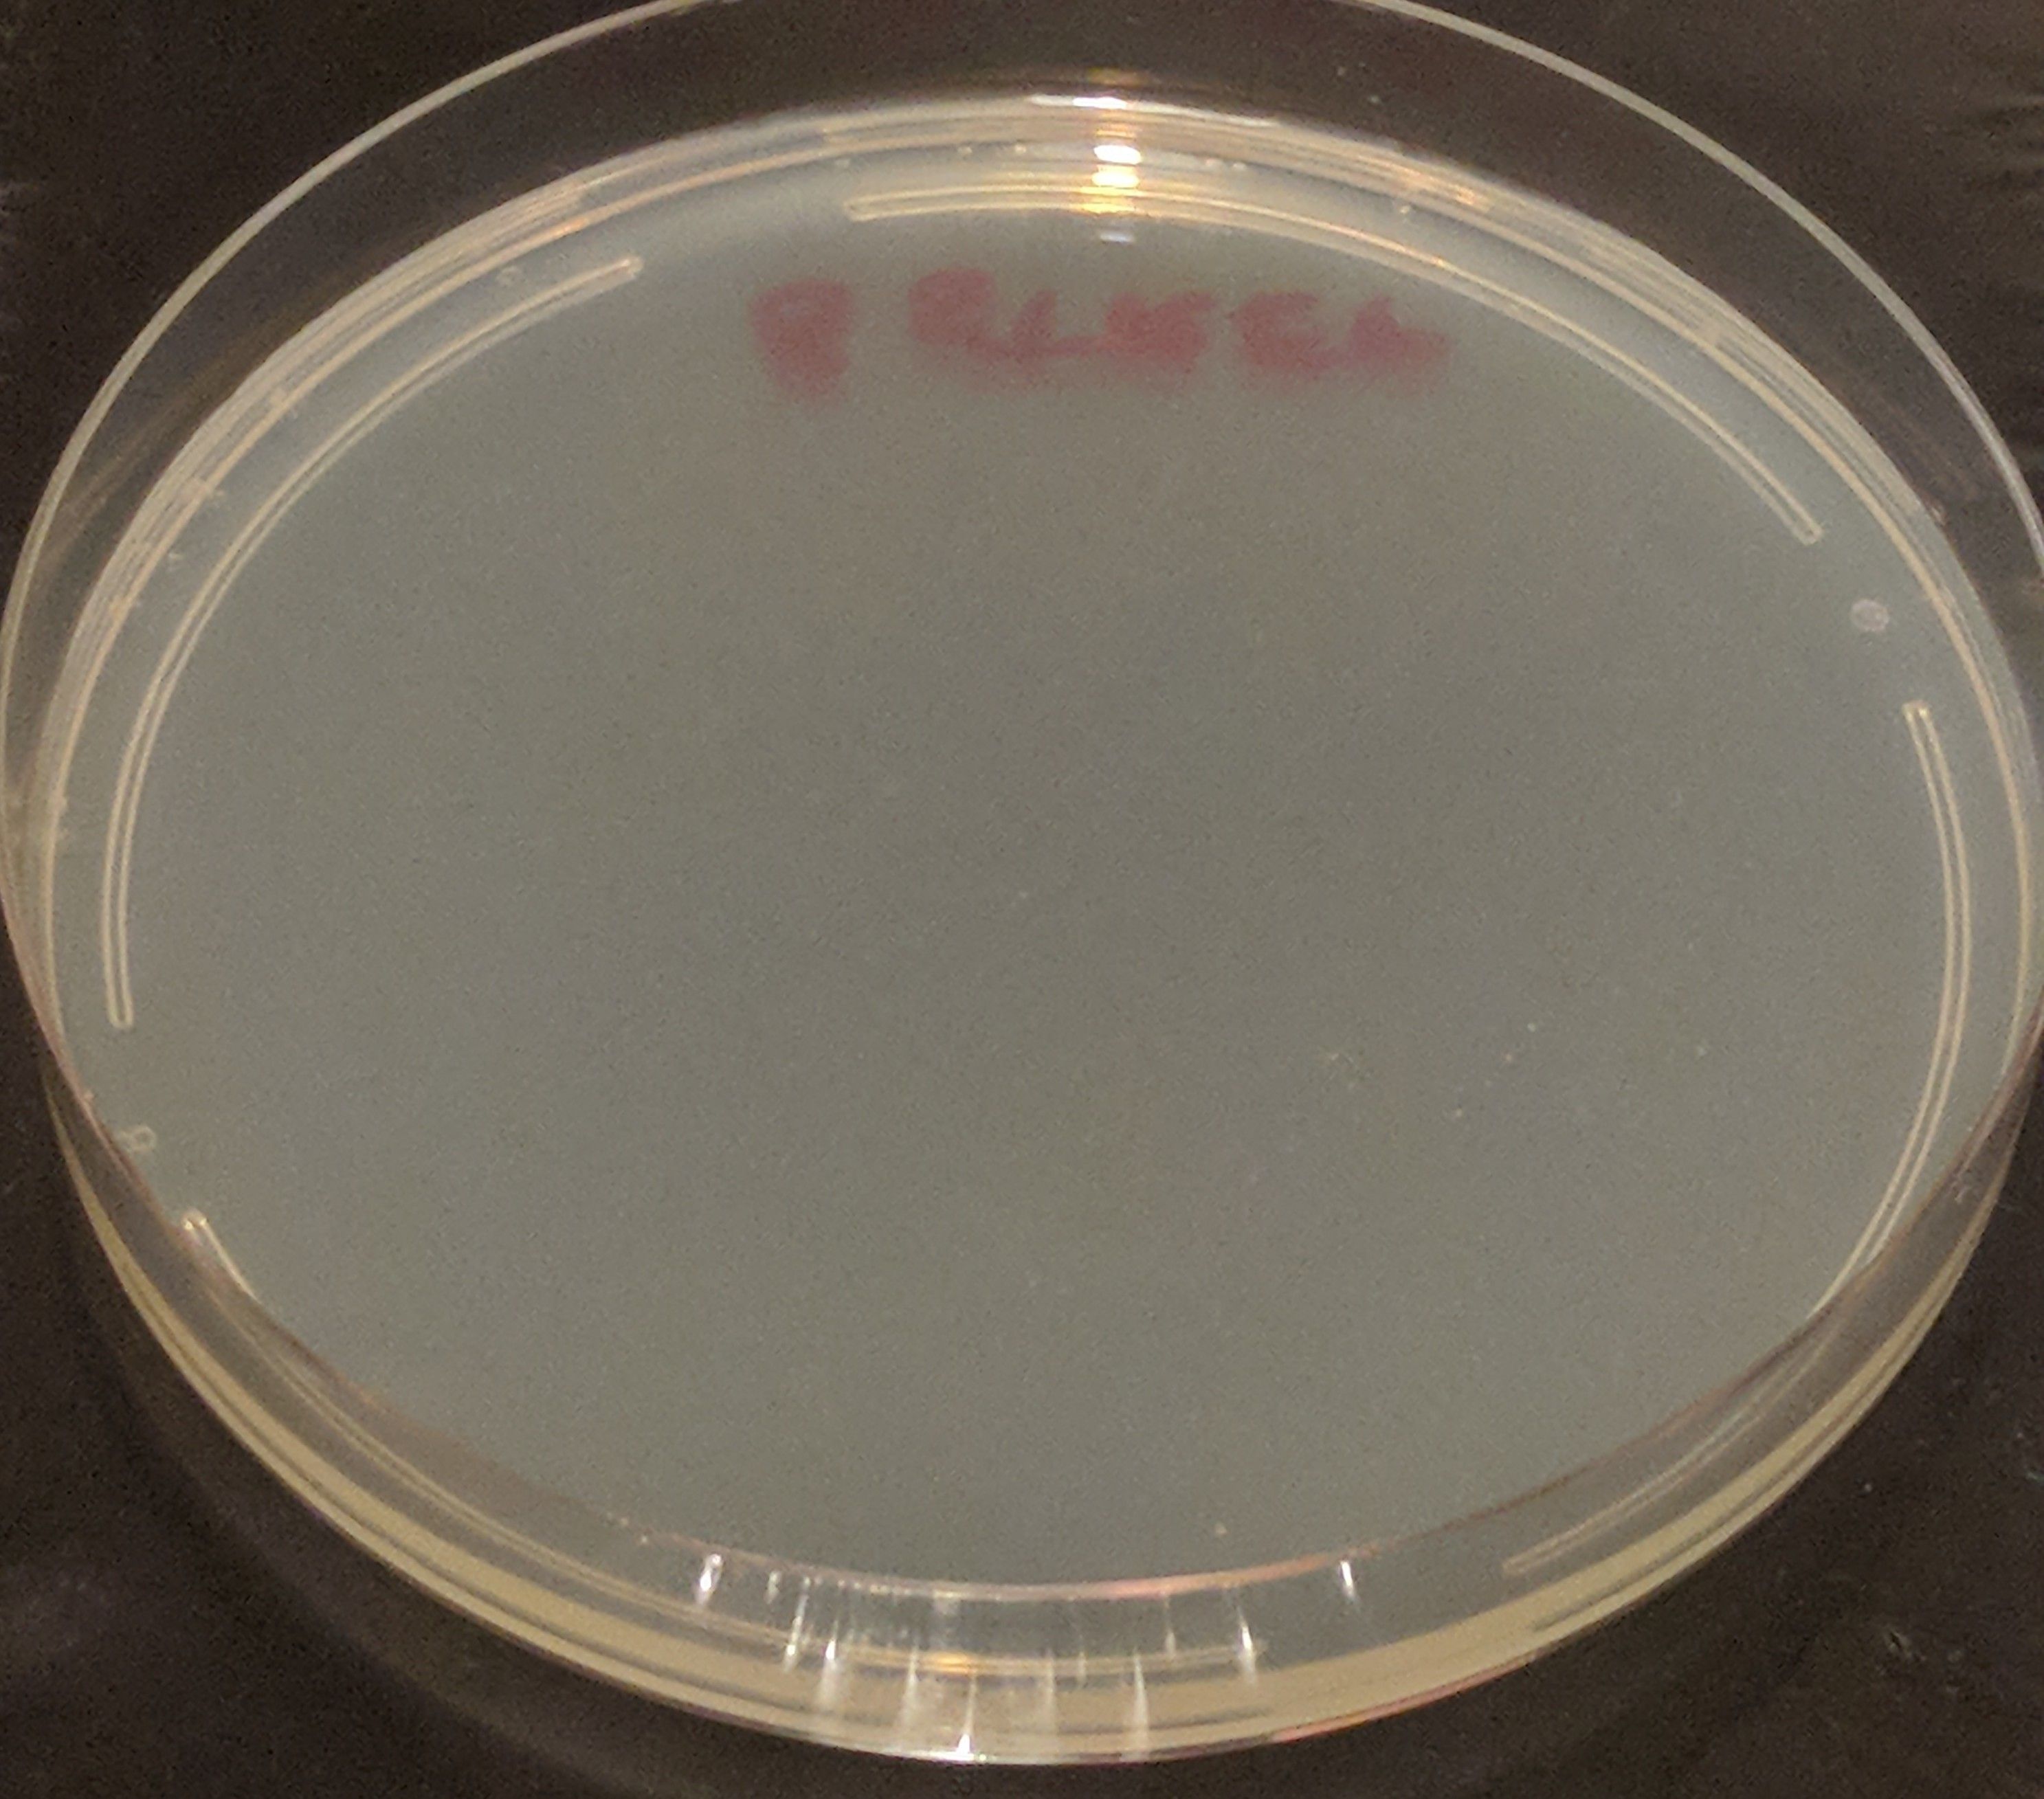
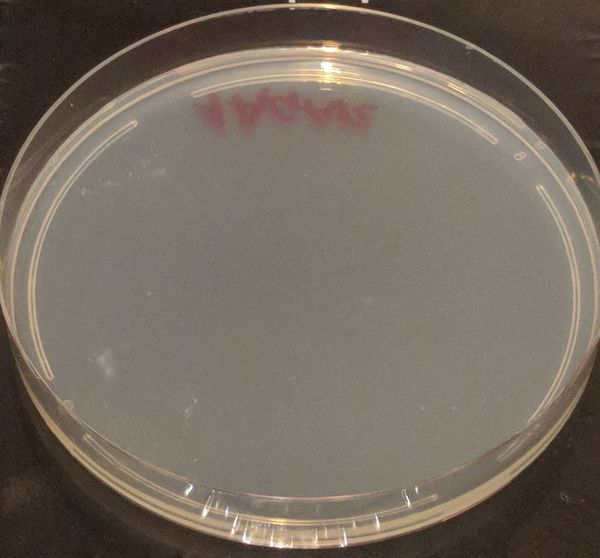
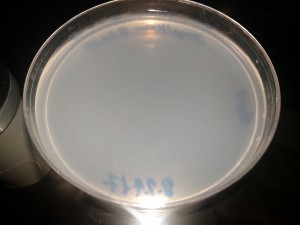
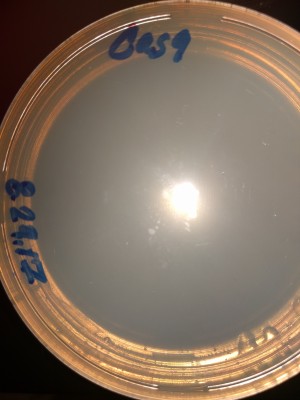
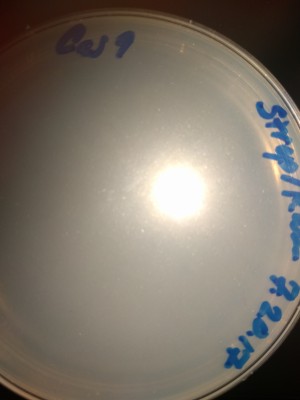
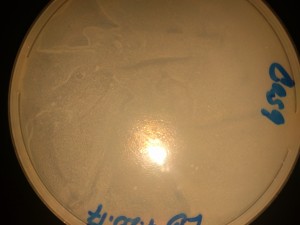
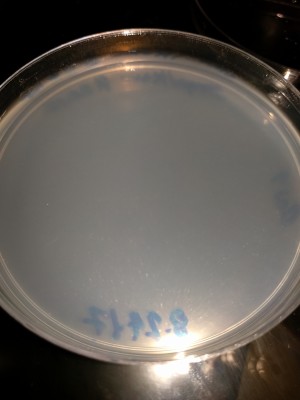
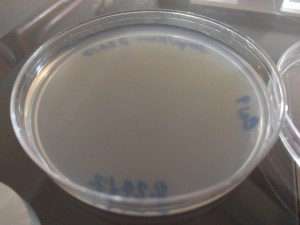

File list
This special page shows all uploaded files.
| Date | Name | Thumbnail | Size | User | Description | Versions |
|---|---|---|---|---|---|---|
| 13:45, 20 February 2023 | Example GNS3.png (file) | ![]() |
52 KB | Max | 1 | |
| 00:02, 10 March 2020 | Velleman-HQ-PS1503SBU.djvu (file) | 135 KB | Ubuntourist | Velleman HQ Power PS1503SBU Power Supply | 1 | |
| 02:03, 18 February 2020 | Tektronix-TDS-224.djvu (file) | 780 KB | Ubuntourist | Tektronix TDS-224 Digital Real-Time Oscilloscope User Manual | 1 | |
| 01:35, 18 February 2020 | Wavetek Model 801 50MHz Pulse Generator.djvu (file) | 352 KB | Ubuntourist | Wavetek Model 801 50MHz Pulse Generator User Manual (9 pages) | 1 | |
| 12:46, 22 March 2019 | HacDC Network.djvu (file) | 347 KB | Ubuntourist | Diagram of classroom network devices and cables, compiled by Bobby 2019.03.18 | 1 | |
| 06:31, 10 July 2018 | SONY 1 8OO 498 99O8.pdf (file) | 100 KB | Ck177200 | 1 | ||
| 22:58, 2 July 2018 | 2790 2Ond.jpg (file) | ![]() |
20 KB | Halter007 | 1 | |
| 19:48, 2 July 2018 | Hp printer customer service+1844~423-5991 hp printer tech support number.pdf (file) | 134 KB | Guzoyaja | 1 | ||
| 19:46, 2 July 2018 | Hp tech support 18444235991 Hp Printer support phone number.pdf (file) | 42 KB | Guzoyaja | 1 | ||
| 04:53, 19 June 2018 | Spaceblimp7 HackersSLS GSBC-Report.pdf (file) | 10.29 MB | Summakor | Spaceblimp 7 (teams Hackers SLS) Global Space Balloon Challenge report. | 1 | |
| 02:24, 29 May 2018 | Dc.svg (file) | 837 bytes | Ubuntourist | Power Supply / Power Adaptor DC marking | 1 | |
| 01:19, 29 May 2018 | Positive Tip Plug.svg (file) | 3 KB | Ubuntourist | Positive Tip Plug https://commons.wikimedia.org/wiki/File:Positive_Tip_Plug.svg https://en.wikipedia.org/wiki/Public_domain | 1 | |
| 01:10, 29 May 2018 | USB Type-B receptacle.svg (file) | 1 KB | Ubuntourist | USB 1.0 Type-B receptacle https://en.wikipedia.org/wiki/USB#/media/File:USB_Type-B_receptacle.svg https://creativecommons.org/licenses/by-sa/4.0/ | 1 | |
| 01:05, 29 May 2018 | USB Type-A receptacle.svg (file) | 1 KB | Ubuntourist | USB 1.0 Type-A receptacle https://commons.wikimedia.org/wiki/File:USB_Type-A_receptacle.svg https://creativecommons.org/licenses/by-sa/4.0/ | 1 | |
| 22:50, 27 April 2018 | Sb7Accelg pop ftime.png (file) | ![]() |
48 KB | Summakor | Spaceblimp 7 Accelerometer data (total XYZ) at Balloon Pop | 1 |
| 21:58, 27 April 2018 | Sb7Delay ftime.png (file) | ![]() |
130 KB | Summakor | Spaceblimp 7 Accelerometer Measurement Delay Flight Time | 1 |
| 21:51, 27 April 2018 | Sb7Blue fltime.png (file) | ![]() |
43 KB | Summakor | Spaceblimp 7 Sky Blueishness (B/RBG) Flight Time | 1 |
| 21:49, 27 April 2018 | Sb7Lux ftime.png (file) | ![]() |
37 KB | Summakor | Spaceblimp 7 Illumination Flight Time | 1 |
| 21:47, 27 April 2018 | Sb7T ftime.png (file) | ![]() |
52 KB | Summakor | Spaceblimp 7 Temperature Log Flight Time | 1 |
| 21:46, 27 April 2018 | Pglitch ftime.png (file) | ![]() |
35 KB | Summakor | Spaceblimp 7 Pressure Log glitch | 1 |
| 21:45, 27 April 2018 | Sb7P ftime.png (file) | ![]() |
44 KB | Summakor | Spaceblimp 7 Pressure Log vs Flight Time | 1 |
| 19:23, 27 April 2018 | SbPressure glitch.png (file) | ![]() |
41 KB | Summakor | Spaceblimp 7 pressure log glitch | 1 |
| 19:04, 27 April 2018 | Sb7Pressure index.png (file) | ![]() |
42 KB | Summakor | Spaceblimp 7 pressure log | 1 |
| 17:05, 17 April 2018 | Sb7 flight path.jpg (file) | ![]() |
95 KB | Nick b | 1 | |
| 22:14, 16 April 2018 | Sb7 peak.jpg (file) | ![]() |
96 KB | Nick b | 2 | |
| 14:17, 10 April 2018 | CFC App Payment 2018.png (file) | ![]() |
58 KB | Summakor | Statement showing payment of 2018 Combined Federal Campaign application fee by Enrique on 1/31/18 on card x8694. Receipt from CFC would be sent to treasurer@hacdc.org. | 1 |
| 02:01, 27 January 2018 | CRISPR-180112-StrepKan CrisprBact 48h.jpeg (file) | ![]() |
554 KB | Summakor | Plate 8, Strep-Kan Agar, after being swirled with modified bacteria and growing for 48 hours. No growth is observed, unlike in plain Agar. The result suggests the bacteria survived the procedure but their genome was NOT modified to be resistant to stre... | 1 |
| 01:59, 27 January 2018 | CRISPR-180112-Agar Bact 48h.jpeg (file) | ![]() |
474 KB | Summakor | Plate 1, plain Agar, after being swirled with modified bacteria and growing for 48 hours. The result shows a significant number of bacteria survived the transformation process and grow on plain Agar as expected. | 1 |
| 01:56, 27 January 2018 | CRISPR-180112-StrepKan blank 48h.jpeg (file) | ![]() |
509 KB | Summakor | Plate 8, Strep-Kan Agar, after sitting at ambient temperature for 48 hours. No growth is observed, showing no contamination was introduced in the preparation. | 1 |
| 01:55, 27 January 2018 | CRISPR-180112-Agar blank 48h.jpeg (file) | ![]() |
37 KB | Summakor | Plate 1, plain Agar, after sitting at ambient temperature for 48 hours. No growth is observed, showing no contamination was introduced in the preparation. | 1 |
| 00:02, 16 January 2018 | OBi110QSG.pdf (file) | 4.93 MB | Ubuntourist | OBi-110 VoIP Quick Start Guide | 1 | |
| 23:57, 15 January 2018 | DIR-817LW-UserManual.pdf (file) | 30.28 MB | Ubuntourist | D-Link DIR-817LW Wireless Access Point User Manual | 1 | |
| 23:53, 15 January 2018 | DIR-817LW-QuickStart.pdf (file) | 988 KB | Ubuntourist | D-Link DIR-817LW Wireless Access Point Quick Start Guide | 1 | |
| 11:14, 21 December 2017 | Lewls.jpg (file) | ![]() |
104 KB | Lewlking | 1 | |
| 11:23, 19 December 2017 | Gmail-Customer-Service.mp4 (file) | 5.7 MB | Johnandy | Gmail customer service is one of the place which response of taking care of the Gmail. Gmail customer need by providing a give professional, excellent, helpful and best assistance before at the time and after the customer requirements are met. Gmail he... | 1 | |
| 15:10, 23 November 2017 | HacDC-CharterMember.jpg (file) | ![]() |
2.61 MB | Ubuntourist | Cropped and rotated | 2 |
| 14:14, 9 October 2017 | HacDC 2017-9 Projects.pdf (file) | 62 KB | Summakor | Project Awesome project earmark balances September 2017 | 1 | |
| 14:12, 9 October 2017 | HacDC 2017-9 Report.pdf (file) | 92 KB | Summakor | Financial report for September 2017. | 1 | |
| 00:39, 8 September 2017 | HacDC 2017-8.pdf (file) | 80 KB | Summakor | Financial statement for August 2017 YTD. | 1 | |
| 01:22, 29 August 2017 | IMG 20170827 093620s.jpg (file) | ![]() |
14 KB | Summakor | CRISPR Strep-Kan Plate 8/27 at 9AM | 1 |
| 01:18, 29 August 2017 | IMG 20170825 190912s.jpg (file) | ![]() |
37 KB | Summakor | CRISPR Strep-Kan Plate 8/26 at 7PM | 1 |
| 01:08, 29 August 2017 | IMG 20170825 001628s.jpg (file) | ![]() |
26 KB | Summakor | CRISPR LB-Agar Plate 8/25 12AM | 1 |
| 01:07, 29 August 2017 | IMG 20170825 001648s.jpg (file) | ![]() |
19 KB | Summakor | CRISPR Strep-Kan Plate 8/25 12AM | 1 |
| 01:03, 29 August 2017 | IMG 20170825 190805s.jpg (file) | ![]() |
15 KB | Summakor | CRISPR LB-Agar Plate 8/25 7PM | 1 |
| 01:02, 29 August 2017 | IMG 20170826 032748s.jpg (file) | ![]() |
20 KB | Summakor | CRISPR Strep-Kan Plate 8/26 3AM | 1 |
| 01:01, 29 August 2017 | IMG 20170826 095042s.jpg (file) | ![]() |
15 KB | Summakor | CRISPR Strep-Kan Plate 8/26 10AM | 1 |
| 14:58, 18 August 2017 | Fullish.png (file) | ![]() |
11 KB | Ubuntourist | A screenshot of the result produced by fullish.scad | 1 |
| 14:56, 18 August 2017 | Fullish.scad (file) | 15 KB | Ubuntourist | A combination of bottom.scad and top.scad, both produced from SVGs obtained by munging an STL file. | 1 | |
| 13:24, 18 August 2017 | Bottom.svg (file) | 5 KB | Ubuntourist | SVG produced from OpenSCAD projection() of HST double-bolt bowden extruder V4 STL file. | 1 | |
| 01:29, 18 August 2017 | Assembly v4 rev3.png (file) | ![]() |
18 KB | Ubuntourist | HST double bolt bowden extruder V4 assembly | 1 |